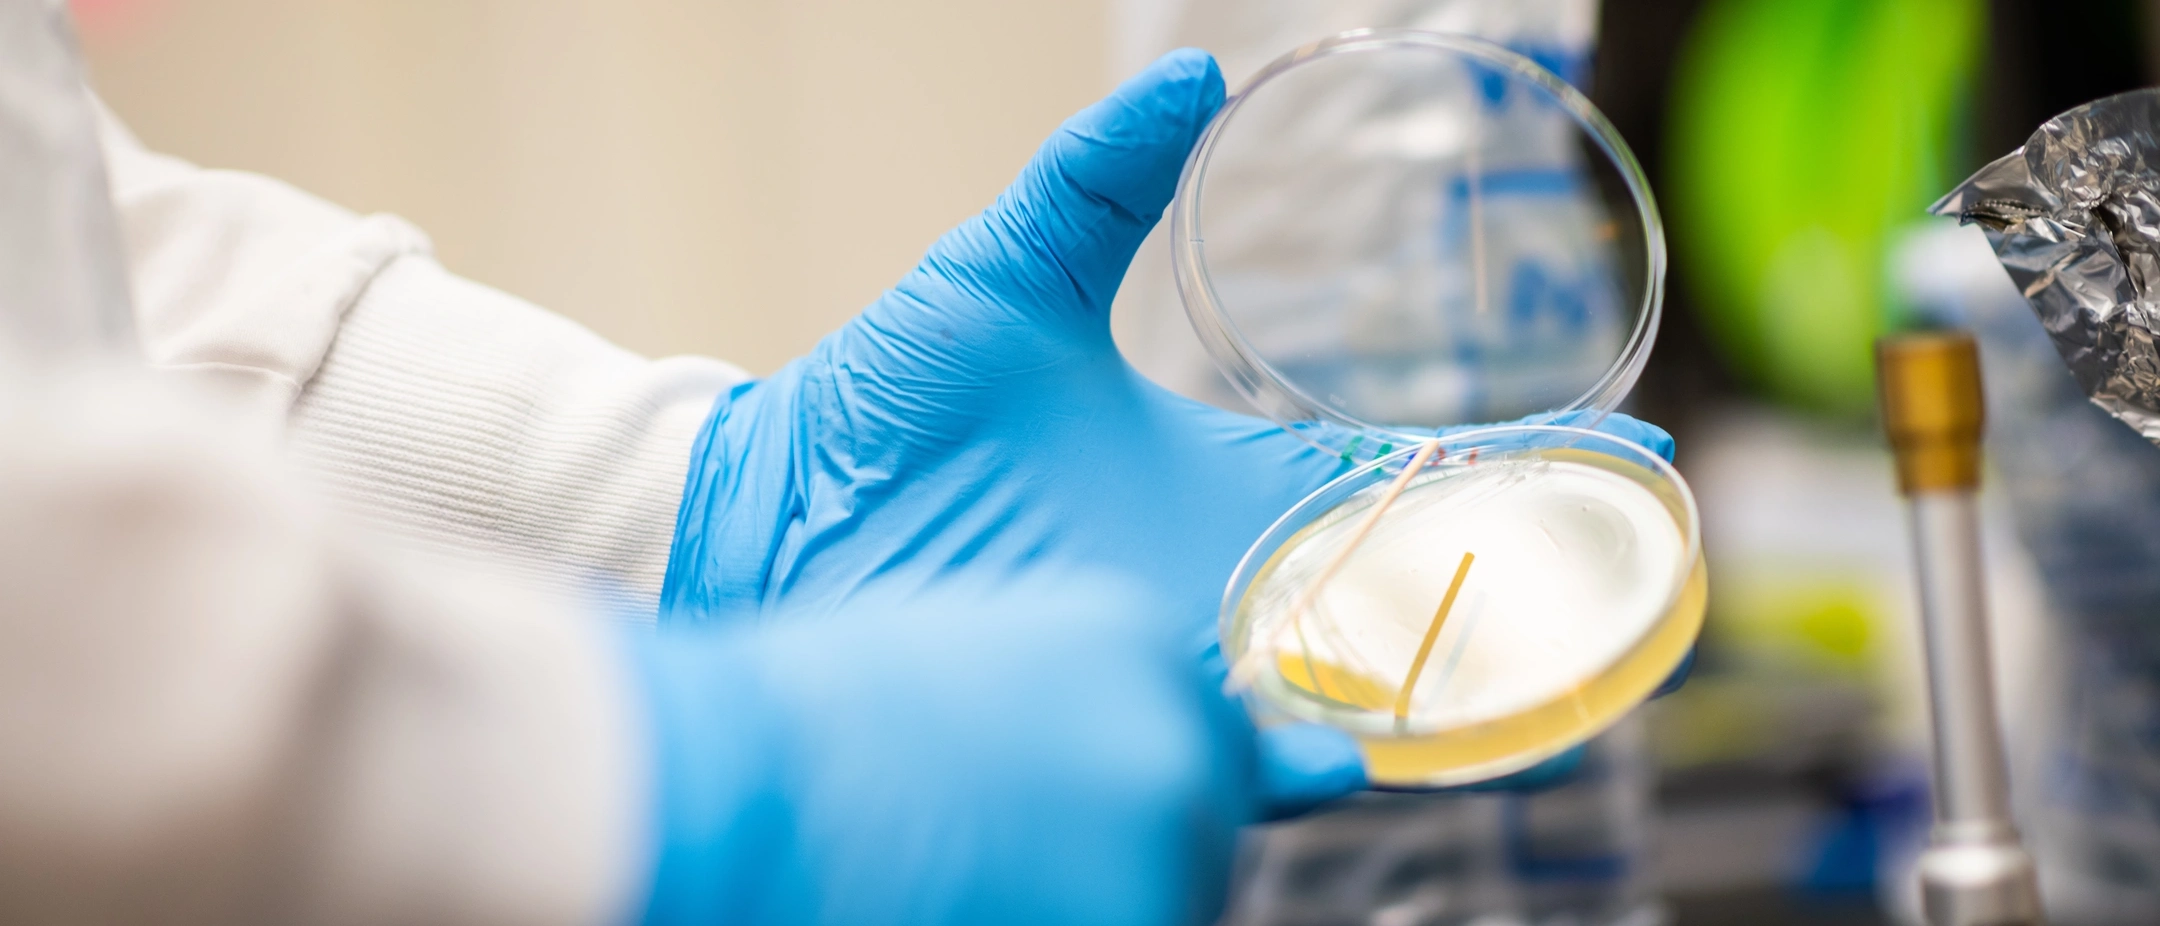
Biology

ALGOMA UNIVERSITY
CANADA

About Algoma University
The Algoma difference is rooted in more personal experiences. Being immersed in diverse world views is transformative. This is learning that enables us to create even greater impact, together. At Algoma, you’ll have access to endless opportunities inside and outside the classroom, allowing for personal growth. You’ll learn from our spirited faculty and benefit from one-on-one interactions – that’s the Algoma advantage. Visit the school page to know more…
Major Courses for Easy Entry
Best advised you choose any course within these major areas of study as it will help prepare you for the job demands in the global market of our world today. See list of courses for Undergraduate and Graduate programs if your choice of course is not listed among the selected courses for major entry.
Undergraduate Programs
“This program is designed to teach students how to be scientists. The skills required in science, the careful use of research, experimentation and logic, with an understanding of statistics and parsimony, are those that our students can apply to in many aspect of their lives. Their past graduates have pursued a career path in research, healthcare, education, environmental management and conservation, museums, aquariums, zoos, parks, nature centers, biotechnology, forensic science, politics and policy, economics, business and industry, science writing, communication, and many more. The rest is yours to discover!”
“By studying Business Administration at AU, students will be given multiple opportunities to network and build upon their connections in the business world. AU’s business administration faculty are experts in the field. Rather than just being educated in business, our professors have experienced risk and success in the world of work. From chartered accountants to certified management accountants, presidents of influential organizations and everything in between. Our faculty are experts in the business world, and have practical and working hands-on knowledge which they bring to the classroom on a daily basis.”
“Students studying Computer Science will gain a strong theoretical and practical foundation in the study of algorithms, programming languages, hardware architecture, systems software, application software, and tools. They will also develop a solid foundation in data structure, programming, assembly language programming, computer organization, operating systems, theory, software engineering, and computer networking. Students also have the opportunity to explore their individual interests and take courses in artificial intelligence, human-computer interactions, and web data management among others!”
“This program concentrates on theory, applications, and explorations in current and policy-related issues at the regional, national, and international level. Students will study the roles of governmental, business, and financial institutions, as well as individuals as they interact with to determine the distribution of a country’s total range of goods and services. Courses cover a wide array of topic areas, including environmental economic policies, microeconomics, urban economics, economic development, economics of finance, elementary and statistical methods for economists, among others.”
“AU’s four-year Bachelor of Arts in Finance and Economics is a unique program, different from other university programs found across the province. Their faculty is committed to a hands-on learning experience where students are able to establish a personal relationship with their professors. This fosters a very intimate and interactive learning environment.”
“This program offers two different degrees, tailored to the students’ strengths and interests. The Bachelor of Science (BSc four-year) degree requires students to complete a greater number of biological-based courses compared to the Bachelor of Arts (BA four-year) degree. A psychology degree is really a stepping stone to the next phase of a student’s life. We teach you how to be dedicated, motivated, and to think critically about scientific data, human and non-human behavior, and science in general.”
Postgraduate Programs
“With a special focus on effective science communication, the master of science in biology program is a research thesis-based program designed for graduates of four-year B.Sc. programs. The program learning outcomes broadly encompass developing critical thinking, analytical, and communication skill sets while expanding and advancing knowledge in the field of biological sciences.”
“This course-based master of computer science program is designed for bachelor’s degree graduates in computer science, information technology (IT) and related areas. Its applied aim is to prepare students to develop expertise with sufficient breadth and depth in the areas of software engineering, cybersecurity, software systems, data analytics, artificial intelligence and IT.”
“This innovative course-based master’s program, offered in Brampton and Sault Ste. Marie, helps students build critical thinking, communication, and analytical skills needed to navigate today’s complex global business and economic landscape.”
“The (MSBA) program at AU equips students with advanced analytical skills to excel in today’s data-driven business world. This program combines data science, business intelligence, and informed decision-making, preparing graduates for careers in analytics, consulting, and research.”